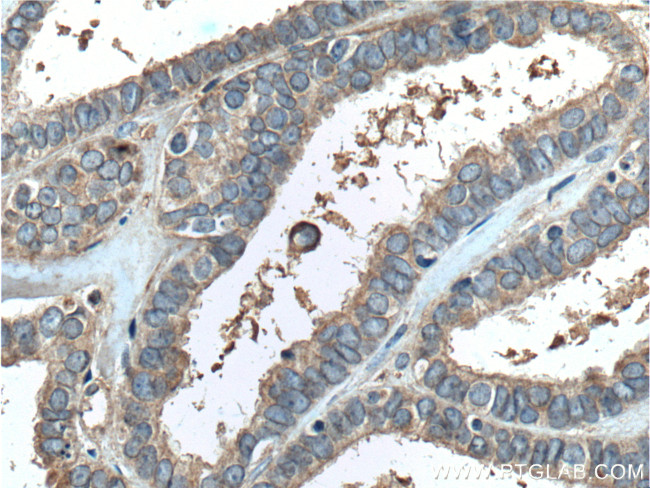
PGRMC1 Antibody in Immunohistochemistry (Paraffin) (IHC (P))
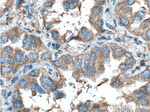
PGRMC1 Antibody in Immunohistochemistry (Paraffin) (IHC (P))

Search
Proteintech
PGRMC1 Monoclonal Antibody (1C10D11)
{{$productOrderCtrl.translations['antibody.pdp.commerceCard.promotion.promotions']}}
{{$productOrderCtrl.translations['antibody.pdp.commerceCard.promotion.viewpromo']}}
{{$productOrderCtrl.translations['antibody.pdp.commerceCard.promotion.promocode']}}: {{promo.promoCode}} {{promo.promoTitle}} {{promo.promoDescription}}. {{$productOrderCtrl.translations['antibody.pdp.commerceCard.promotion.learnmore']}}
产品信息
66372-1-IG
种属反应
宿主/亚型
分类
类型
克隆号
抗原
偶联物
形式
浓度
规格
纯化类型
保存液
内含物
保存条件
运输条件
产品详细信息
Immunogen sequence: YKIVRGDQP AASGDSDDDE PPPLPRLKRR DFTPAELRRF DGVQDPRILM AINGKVFDVT KGRKFYGPEG PYGVFAGRDA SRGLATFCLD KEALKDEYDD LSDLTAAQQE TLSDWESQFT FKYHHVGKLL KEGEEPTVYS DEEEPKDESA RKND (43-195 aa encoded by BC034238)
靶标信息
The protein encoded by this gene is a transforming protein that is related to Rho-specific exchange factors and yeast cell cycle regulators. The expression of this gene is elevated with the onset of DNA synthesis and remains elevated during G2 and M phases. In situ hybridization analysis showed that expression is at a high level in cells undergoing mitosis in regenerating liver. Thus, this protein is expressed in a cell cycle-dependent manner during liver regeneration, and is thought to have an important role in the regulation of cytokinesis.
仅用于科研。不用于诊断过程。未经明确授权不得转售。
生物信息学
蛋白别名: 25-DX; Acidic 25 kDa protein; Dap1; HGNC:16090; IZA; Membrane-associated progesterone receptor component 1; membrane-bound progesterone receptor; mPR; PGRMC1; progesterone binding protein; steroid membrane binding protein; unnamed protein product; VEMA; Ventral midline antigen
基因别名: 25-Dx; 25Dx; AA415812; Dap1; HPR6.6; IZA; Lewi; MPR; PGRMC; PGRMC1; PPMR; VEMA
UniProt ID: (Human) O00264, (Pig) Q95250, (Rat) P70580, (Mouse) O55022
Entrez Gene ID: (Human) 10857, (Pig) 396946, (Rat) 291948, (Mouse) 53328